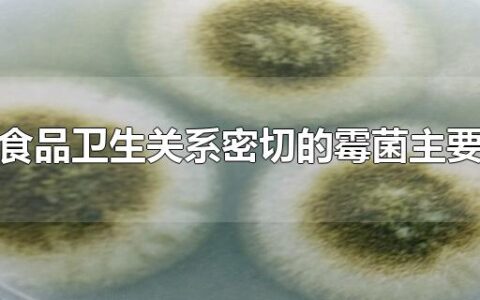
与食品卫生关系密切的霉菌主要有

霉菌
-
超净洗是什么意思?
品牌型号:海尔洗衣机系统:EG100MATE2S 超净洗是洗衣机的功能,用的是比较强力方式,确保洗出来的衣服更加干净,可以用来清洗一些比较耐磨的衣服,或者是油污比较大的衣服,建议大…
-
皮衣上霉菌斑怎么去除
皮衣上霉菌斑可以用皮革清洁剂去除,用蘸了皮革清洁剂的干净毛巾擦拭霉菌斑即可,也可以用浸了酒精的棉布擦拭皮衣,然后挂在通风处晾干,皮衣擦干后要悬挂在衣柜里,可以在口袋中放包樟脑丸防虫…
-
腊肉可以一直挂在外面吗
腊肉可以一直挂在外面,但是要保持通风阴凉的环境,而到了春夏季节后应该做好降温措施,以免温度过高造成腊肉变质,腊肉也可以放在冰箱进行冷冻,可以保留其中的一些水分,口感会更佳,如果腊肉…
-
甲基氯异噻唑啉酮是什么
杀菌防腐剂。可以有效杀灭藻类、 细菌和真菌。耐热之水性防腐剂,对于抑制微生物的生长有很好的作用,可以抑制细菌、真菌、霉菌及霉菌的生长。 该单活性剂可广泛应用于工业冷却水、油田回水槽…
-
自制辣椒酱怎么才能让保质期长
想要自制的辣椒酱有较长的保质期,可以在制作的时候加入一些蒜末,能起到杀菌消毒的作用。可以在制作好的辣椒酱在上面封一层油,这样不仅能够增香气,而且还能够阻绝空气与辣椒酱接触,防止其发…
-
褚橙产地是哪里的
褚橙产地是云南。褚橙属甜橙类,形状为圆形,颜色为橙黄色,是云南著名的特产,以味甜皮薄著称,在南方各省均有分布,以云贵川、广东、台湾等地区栽培较为集中,是由昔日烟王红塔集团原董事长褚…
-
与食品卫生关系密切的霉菌主要有
与食品卫生关系密切的霉菌主要有曲霉菌属、青霉菌属和镰刀菌属。霉菌是真菌的一种,其特点是菌丝体较发达,无较大的子实体。同其他真菌一样也有细胞壁,以寄生或腐生方式生存。霉菌是形成分枝菌…
-
内裤可以和衣服一起放洗衣机洗吗
内裤是可以和衣服一起洗,但手洗会更好,或者说是私有的洗衣机,公共洗衣机就不要放进去洗了。再者洗衣机环境比较潮湿,容易滋生细菌、霉菌,一起洗有可能将霉菌沾到内裤上,引起交叉感染。 清…
-
阿胶糕变质是什么样的 阿胶糕不拉丝是不好吗
阿胶糕尝起来有点苦是正常的。这是因为阿胶糕的原料是阿胶和黄酒,使得制作的阿胶糕略带苦味。另外,在制作电子阿胶糕时,如果长时间烹饪电子饺子蛋糕,会使制作的电子饺子蛋糕变苦。下面,就快…
-
如何判断普洱茶发霉了
1、发霉的普洱茶,其表面会有霉菌。2、发霉的普洱茶,闻起来有刺激的霉味。3、发霉的普洱茶,颜色会变黑。4、发霉的普洱茶,喝起来的味道会怪异。这些都是普洱茶发霉的迹象。 如何判断普洱…